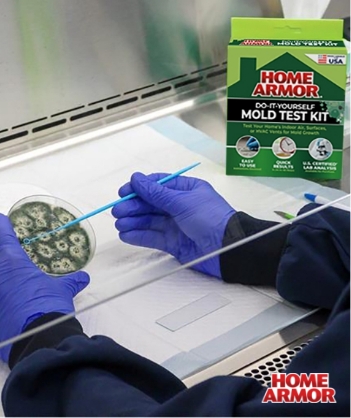

Innovative cleaning solutions formulated to keep your outdoor spaces clean.
Blasts away stains from mold, mildew, algae, dirt, and grime
Visible results in seconds
Safe around plants when used as directed
Safe to use on most outdoor surfaces
Power Clean Wand Technology
2X the cleaning power of ordinary outdoor cleaners.
Outdoor Cleaner+
Featuring Clean+ sprayer setting for a deeper clean on tougher surfaces & stains.
Buy Lab Analysis for At-Home Mold Test Kit
Looking for more a full analysis of your at-home mold test results? Purchase our Lab Analysis to determine the type and severity of mold in your testing location. Just send us the sample you collected and we’ll do the rest.
Explore Our Products
Home Armor products are formulated to work on a variety of outdoor surfaces to deliver visible results in seconds. Click on each of the products below to learn more.

Shop at your local and online retailers.
Available at select retailers in person and online. Availability may vary by location. We recommend checking with your preferred retailer either in-store or on their website to confirm that the product you’re looking for is available.